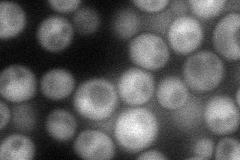
YDR082W
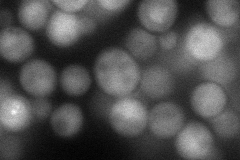
YDR082W

View description
Telomere end-binding and capping protein, plays a key role with Pol12p in linking telomerase action with completion of lagging strand synthesis, and in a regulatory step required for telomere capping
Localization:
Intensity:
Fold change:
Significance:
-
C’ GFP library in SD

below threshold15.16 -
N' NOP1pr-GFP in SD
cytosol,punctate56.6612 -
N' TEF2pr-mCherry in SD
cytosol63.1849 -
N' NATIVEpr-GFP in SD

below threshold19.528 -
N' TEF2pr-VC and Cyto-VN in SD

cytosol33.0276 -
C’ GFP library in SD+DTT

cytosol17.91.18No -
C’ GFP library in SD+H2O2

cytosol14.640.96No -
C’ GFP library in Starvation Media

cytosol14.090.92No -
C’ GFP library on the background of Pup2-DaMP

below threshold -
C’ GFP library on the background of CCT mutant

below threshold18.83461.24121No
